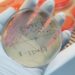
UTIs are still diagnosed using a 140-year-old method – here’s why

EternalMoments/Shutterstock
According to the Office for National Statistics, this summer we’ve seen more deaths registered in England and Wales than expected.
The difference between the actual and expected number of deaths recorded, from any cause, is known as the excess deaths. During the first eight weeks of 2022, despite there being 9,110 deaths documented with COVID mentioned on the death certificate in England and Wales, there were 8,001 fewer total deaths than anticipated.
However, since April this has flipped. Between April 2 and August 19 (granted, a longer period) there were 12,321 deaths registered with COVID on the death certificate but notably, 21,475 excess deaths.
So if COVID accounts for only a little over half of these excess deaths, what may be driving the rest? There are a range of possible explanations, several stemming from the indirect effects of the pandemic.
The first possibility is that some deaths may follow weeks or months after recovery from a severe COVID infection and therefore not be registered as a COVID death. Research has shown that people who have recovered from COVID have had a higher risk of heart disease, for example, and deaths from other causes.
But these studies were based on infections earlier in the pandemic and found that ill health and death were more common in people who were very sick when they had COVID. Whether the same risk applies now with the generally milder acute illness is doubtful.
Another possibility may relate to the secondary effects of COVID control measures, especially lockdowns. Lockdowns were associated with deterioration in health, especially mental health, and healthy behaviour such as exercising and eating well. These negative effects were most marked in vulnerable groups such as older people and those who are severely obese.
There is no evidence that lockdowns early in the pandemic were associated with excess deaths in countries which initially avoided large numbers of COVID infections, such as Australia and New Zealand. But one issue that remains a concern is that the pandemic has reduced activity levels, especially in older people. We know people who do less physical activity have a higher risk of death over time.
There are also concerns that older people are not returning to socialising, and that a resulting lack of social connection may be affecting their health and therefore mortality.
While lockdowns do have consequences for public health, in the early days of the pandemic the benefits in reducing COVID transmission over the negative effects were clear. However, once most people had been vaccinated, the harms of such strict measures started to outweigh the benefits, in my view.
Read more:
Stronger democracies have seen fewer excess deaths during COVID – new research
A further possibility may be the impact of the pandemic on healthcare services. There’s plenty of evidence that the pandemic delayed necessary non-COVID medical care for many people. Early in the pandemic this would have been due to the large number of COVID cases requiring hospital care, but more recently this has primarily been exacerbated by staff having to self-isolate.
Evidence shows that delays in accessing healthcare are associated with increased mortality. A recent study in the English National Health Service found people who had to wait in the emergency room for more than five hours were more likely to die compared to people who were seen within the first five hours. As waits got longer, the risk of death increased.
It is certainly the case that waits in A&E and even in ambulances prior to getting into A&E have increased.

Solarisys/Shutterstock
Beyond COVID
The UK has experienced two severe heatwaves this summer. Heatwaves are associated with increased deaths, especially in older and more vulnerable people. The July heatwave in particular was associated with a marked peak in deaths both among people with COVID and people without COVID. It is too early to know how the August heatwave affected mortality. However, the impact of the July heatwave was short-lived and could not explain the excess deaths over other weeks.
Further, although the link between the state of the economy and increased mortality is complex, there is good evidence that deprivation and economic crises are associated with early death.
While it’s too early for official figures for 2022 to confirm this, poverty in the UK has been predicted to increase this year and next. Recent rises in inflation will probably have accelerated this increase in deprivation and it’s likely that there will be some effect on mortality.
Elevate Your Health for Just $29.99/Month
Join the Precision Wellness Subscription at My Healing 365 and get discounted services, priority coaching access, virtual care, and exclusive wellness resources to support your physical, emotional, and hormonal health.
Join for $29.99/MonthSo there are a range of factors that may have contributed to the rise in excess deaths over recent months, but distinguishing the relative contributions of each cause is not easy. There may also be other factors at work that we have not yet considered.
As we emerge from the acute phase of the pandemic, understanding the causes of these observed excess deaths, and identifying how they can be reduced, could be the next big public health challenge facing the UK.
![]()
Paul Hunter consults for the World Health Organization. He receives funding from National Institute for Health Research, the World Health Organization and the European Regional Development Fund.